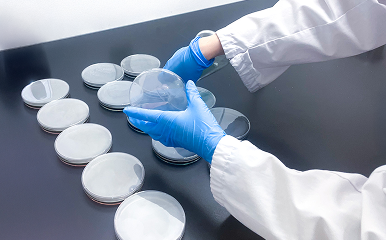

自分の学びが『食の安心・
安全』に繋がることに
やりがいを感じます!
2021年 入社
兵庫工場 生産本部 品質保証課

主な仕事内容
原材料や商品の微生物検査を主に行っています。商品が安全に製造できているかの衛生管理指標となる一般細菌数や大腸菌、黄色ブドウ球菌等、食中毒の原因となる細菌がいないかを検査しています。作業者の手が衛生的かどうかを判断するための検査や空気中の菌の測定なども実施し、製造環境が整っているかを確認しています。また検査を行うだけでなく定期的に工場内にも行き、現場の方々とコミュニケーションを取りながら衛生管理のルール作成や教育訓練も行っています。

1日のタイムスケジュール

仕事のやりがいを感じるとき
専門的な知識が多いことから、日々多くのことを学ぶ必要があり、検査結果によっては品質への影響が出てしまうので、常に正確さが求められる仕事です。
プレッシャーを感じることもありますが、知識として身に付けたことが業務で活かせた際、自分の学びが製品を通じてお客様への『食の安心・安全』に繋がることにやりがいを感じます。

仕事で成功したエピソード
以前まで製品検査は外部委託していましたが、私が検査業務に携わってからは外部委託費用を削減することができました。また外部委託することで検査結果が分かるまで1週間ほどかかりましたが、社内で検査を行うことで2~3日で結果が分かることから、検査の迅速化にも成功しました。
仕事の今後の目標
品質保証に関する知識を深めていき、どんな業務でも任せてもらえるようになることが目標です。また得た知識によってさらなる製造環境の向上を目指して、お客様へ『食の安心・安全』を届けるよう努めてまいります。

